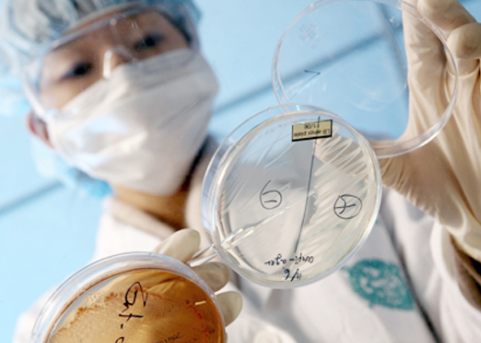

반갑습니다. 이번 포스팅에서는 첨생법 관련주에 대해서 한번 알아보려고 하는데요.
우선 첨생법은 다들 아시겠지만 첨단재생의료법을 뜻합니다.
첨생법은 간단히 말해서, 재생의료와 관련된 임상연구를 진행했을때 심사기준을 완화해주는 법안입니다.
그러면 이 심사기준을 완화가 되었을때 결과적으로 재생의료 업계의 바이오의약품 개발기간이 최고 3~4년은 단축 될 것으로 기대가 되는데요.
첨생법이 본격 시행 되면서 바이오 주식관련해서 우리는 계속 지켜봐야 될 것 같습니다.

자 이제 첨생법에 대한 것이 무엇인가 그리고 앞으로의 미래가망성과 우리가 지켜봐야할 첨생법 관련주에 대해서 한번 알아보겠습니다.
첨생법이란?

우선 첨생법은 앞서 말씀드렸듯이 첨단 재생의료법을 말하는데요.
첨단 재생의료법의 적용범위는 사람의 신체구조 기능을 재생,회복 질병 치료, 예방 그리고 줄기세포 등과 같은 세포치료 등과같은 바이오 의학관련이라고 이해하시면 될 것 같습니다.
무조건 재생의료기술이라고 첨생법의 혜택을 받는 것은 아니고 연구를 했을때 정부가 지정한 일부 요건을 충족시켜야 합니다.
일정요건을 통과하게 되면 기존 바이오의학 심사기준을 완화하여, 맞춤형 심사를 받을 수 있고, 보다 손쉽게 허가를 받을 수 있습니다.
사실 의약품이 시중에 유통되기까지는 엄청난 시간과 비용이 드는 것은 다들 아실 것 같습니다.
하지만 첨생법이 통과가 되어 보다 빠르게 신약개발을 할 수 있어 앞으로의 바이오의약회사와 의약품의 발전이 보다 빠르게 이루어질 것으로 보입니다.
첨생법으로 보는 바이오업계 미래가망성






첨생법을 통해 의약회사는 엄청난 시간과 비용을 아낄 수 있는 방법을 마련했습니다. 물론 일부 요건을 충족시켜야 완화되는 부분은 있는데요.
하지만, 앞으로 바이오회사에서는 자기네들의 손해를 줄이고 보다 빠르게 신약개발을 하기 위해서 조금 더 타겟팅을 해서 신약개발하는 것을 목표로 할 것으로 보입니다.
특히 희귀질환 관련 의약품의 경우, 보다 효율적이게 첨생법의 효과를 볼 수 있는 것이 아닐까 싶습니다.
첨생법 관련주
자 이제 첨생법 관련주에 대해서 한번 알아보겠습니다.
1. 파미셀


우선 파미셀에 대해 소개해드려야 될 것 같습니다. 첨생법의 대장주라고도 볼 수 있는데요.
파미셀은 지난 1968년 설립되었고, 바이오사업부와 케이컬사업부 2개의 사업부로 나뉘어져있습니다.
파미셀은 잘 아시다시피 코로나 관련주로도 유명한데요. 줄기세포 관련 치료제 전문인만큼 파미셀은 첨생법 관련주, 코로나 관련주로 관심있게 지켜보셔야 할 바이오 회사 중 하나 인 것 같습니다.
2. 에스씨엠생명과학


두번째로는 에스씨엠생명과학으로 보시면 될 것 같습니다. 독자개발 플랫폼 줄기세포 분리와 치료제 기술을 보유하고 있는 업체입니다.
줄기세포 관련으로 지난 미국과 이탈리아의 바이오 회사들을 차례로 인수하였으며, 줄기세포 치료제 개발의 선두주자라고 보시면 될 것 같습니다.
2022년에 만성 이식편대숙주질환 치료제 후보 물질이 조건부로 허가가 될 예정이라 두고봐야할 주식인 것 같습니다.
3. 안트로젠


마지막으로 안트로젠입니다. 안트로젠 또한 줄기세포를 이용한 치료제 개발과 당뇨관련 치료를 위한 임상시험을 진행중에 있습니다.
지난 5월 당뇨병성 족부궤양 치료제가 첨단재생의료치료제로 지정된 만큼 잠재력 있는 첨생법 관련주로 보입니다.



마무리



자 오늘은 이렇게 첨생법 관련주에 대해서 한번 알아봤습니다.
첨생법은 바이오 관련이기 때문에 어떻게 보면 복불복의 기운도 있기는 하지만 코로나로 인해 관련 수혜주들이기도 한만큼 잘 지켜보셔서 투자를 끌고갈지 말지 결정하셔야 되는 부분이 아닐까 싶습니다.
감사합니다.
'정보 > 재테크' 카테고리의 다른 글
| 빅히트 엔터테인먼트 상장 청약일정 총정리! (0) | 2020.09.14 |
|---|---|
| 혈장치료 관련주 (0) | 2020.09.13 |
| 공모주란? (1) | 2020.09.01 |
| 카카오게임즈 공모주 청약방법 정리 (0) | 2020.09.01 |
| 농가주택 매매 혜택정리 (0) | 2020.08.26 |








최근댓글